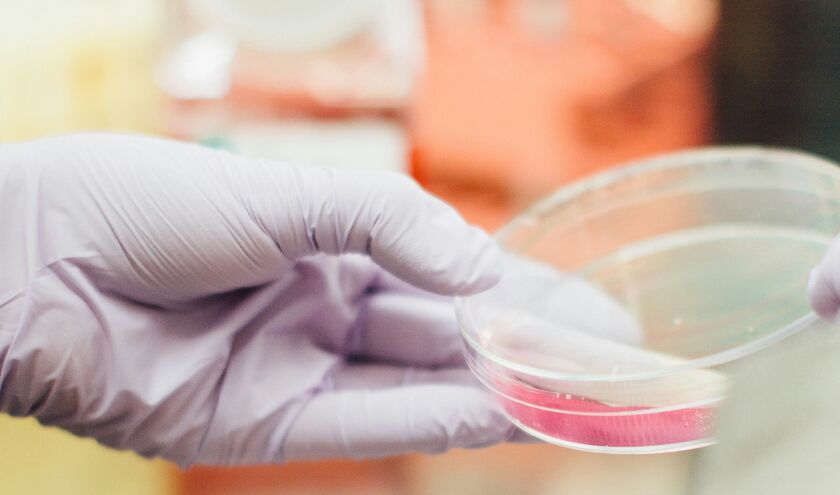
MHRA reforms will speed up path for rare therapies

Central to this reform will be tackling the unique barriers that currently prevent life-changing rare disease therapies from reaching patients, like small patient numbers and difficult evidence generation, while maintaining safety.
Around 3.5 million people in the UK live with a rare disease, yet fewer than 5% of rare diseases currently have an approved treatment. The average diagnostic journey takes 5.6 years, and 30% of affected children die before the age of five.
The cost of delayed diagnosis and limited treatment options is estimated at £340m annually, with a further £4.7bn in health-related disability costs and a £14.9bn annual loss to the economy.
Supporting the development of the reforms is a newly formed Rare Disease Consortium, which includes patients and their representatives, academics and industry.
Currently, each new rare therapy requires a separate route through regulatory approval, including an approval to get the clinical trial set up and then an approval to be marketed in the UK. This approach is costly and inefficient, making it unviable to develop multiple highly targeted treatments. The paper discusses whether an early, single approval could be issued for both a clinical trial application and marketing authorisation based on compelling but limited evidence. This approval would be granted with a strict safety monitoring plan with real-world evidence review at a set frequency.
The paper also sets out:
- how to better share evidence in the UK and globally to pool scarce data
- Whether a single approval could be issued for a therapy, even where there is a variable component tailored to an individual's characteristics
- the importance of strengthened post-market surveillance
- better health system alignment in the UK and internationally.
Julian Beach, MHRA executive director of healthcare quality and access, said: ‘The UK has the ingredients to be a global leader in rare disease therapies, with a rich academic base, a single provider of genomics and the unique, diverse datasets of the NHS. The challenge is bringing all these elements together, which our new framework will do.
‘There is still more work to be done, but I hope this paper reassures all those affected by rare disease that we are listening and are prepared to take bold action to speed the path from discovery to delivery, while maintaining strict standards of safety.'
The MHRA framework won't be published in full until next year.
Reaction
Nick Meade, chief executive of Genetic Alliance UK, said: ‘For too many families, a rare diagnosis comes without a viable cure or treatment. This programme is a vital step towards changing that. Fostering the development of treatments here in the UK will bring direct benefits for people living with rare conditions.
‘We welcome this clear signal of the UK's commitment to becoming a world leader in rare condition therapy development, and our community of rare condition organisations stands ready to lend its expertise to make it a success.'
Dr Rick Thompson, chief executive of Beacon: for rare diseases, said: 'This paper from the MHRA provides hope that a real shift in the UKs approach to caring for the millions affected by rare diseases is possible. The creation of regulatory pathways tailored to the unique challenges posed by rare diseases, and a pragmatic approach to collection of data in the real world is something we have hoped to see for many years.
'Beacon is excited to see what develops in the coming year, and committed to supporting the rare disease patient community to engage with this important work however possible.'
Dr Jacqeline Barry, chief clinical officer at Cell and Gene Therapy Catapult, said: ‘Through this initiative, the MHRA aims to create flexible, science-led regulatory pathways that speed up clinical trials and product approvals for rare disease therapies, while upholding the highest standards of safety, efficacy, and quality.
'These efforts have the potential not only to transform patients' lives, but also to reduce the long-term burden on the NHS.'
Sam Barrell, chief executive of LifeArc, said: ‘We welcome today's announcement, which aims to tackle some of the key challenges holding back new treatments reaching people who need them. If we seize this opportunity and position the UK as a hub for innovative research in rare diseases, the breakthroughs we achieve could also revolutionise care for more common conditions.'
Dr Harriet Holme, founder and executive chair of PCD Research, said: ‘By committing to change the UK's regulatory framework for rare disease therapies, the MHRA is laying the foundation for crucial steps towards ensuring that innovation can safely reach patients faster.
‘By building on the ambitions of the Life Sciences Sector Plan to embed genomics in healthcare, integrating national datasets through the Wellcome NHRS, and aligning with updated regulation, we have a unique opportunity to deliver truly life-changing outcomes for patients. These reforms have the power to make the UK a global leader in rare disease innovation, driving inbound investment, transforming lives and ensuring that no patient is left behind simply because their disease is rare.'